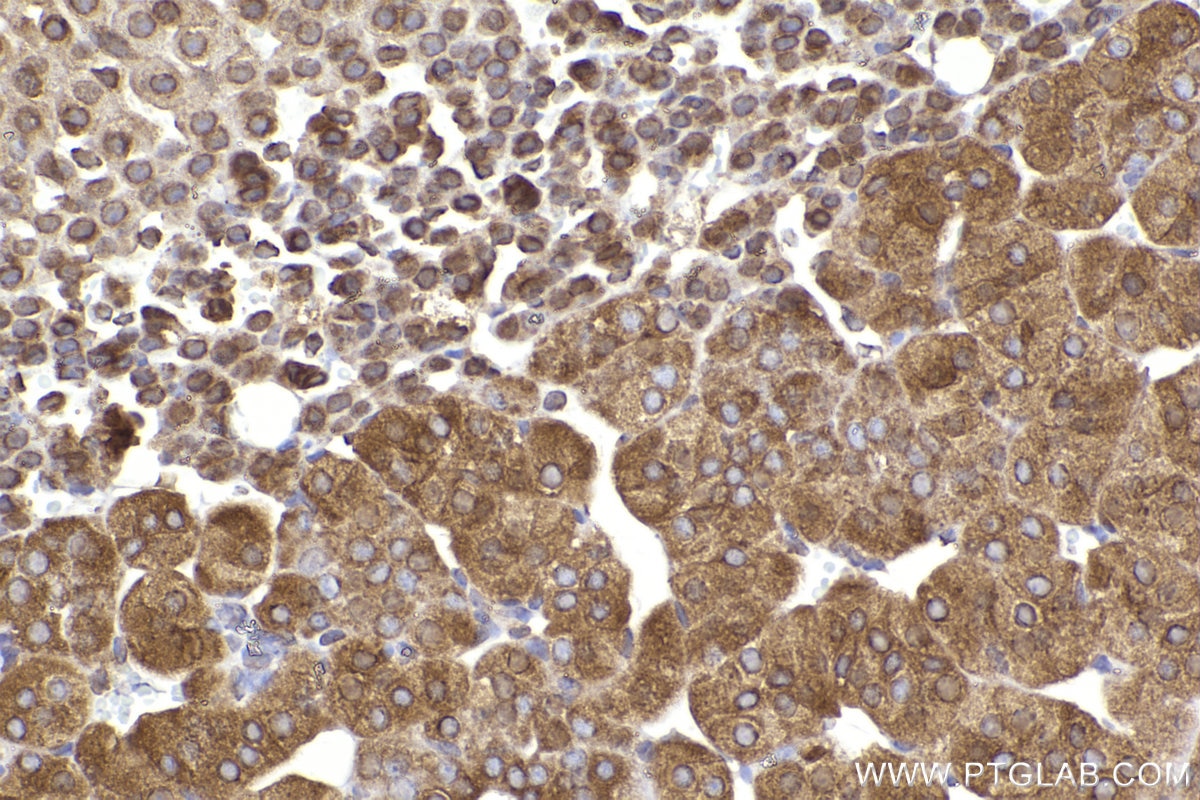
Immunohistochemistry (IHC) staining of mouse adrenal gland tissue using FXR1 Polyclonal antibody (13194-1-AP)

Tested Applications
| Positive WB detected in | HEK-293 cells, mouse heart tissue, NIH/3T3 cells |
| Positive IP detected in | mouse skeletal muscle tissue |
| Positive IHC detected in | human placenta tissue, human heart tissue, mouse adrenal gland tissue Note: suggested antigen retrieval with TE buffer pH 9.0; (*) Alternatively, antigen retrieval may be performed with citrate buffer pH 6.0 |
| Positive IF/ICC detected in | HeLa cells, HepG2 cells |
Recommended dilution
| Application | Dilution |
|---|---|
| Western Blot (WB) | WB : 1:5000-1:50000 |
| Immunoprecipitation (IP) | IP : 0.5-4.0 ug for 1.0-3.0 mg of total protein lysate |
| Immunohistochemistry (IHC) | IHC : 1:1000-1:4000 |
| Immunofluorescence (IF)/ICC | IF/ICC : 1:200-1:800 |
| It is recommended that this reagent should be titrated in each testing system to obtain optimal results. | |
| Sample-dependent, Check data in validation data gallery. | |
Published Applications
| KD/KO | See 7 publications below |
| WB | See 21 publications below |
| IHC | See 1 publications below |
| IF | See 6 publications below |
| IP | See 3 publications below |
| RIP | See 2 publications below |
Product Information
13194-1-AP targets FXR1 in WB, IHC, IF/ICC, IP, RIP, ELISA applications and shows reactivity with human, mouse samples.
| Tested Reactivity | human, mouse |
| Cited Reactivity | human, mouse, rat, pig |
| Host / Isotype | Rabbit / IgG |
| Class | Polyclonal |
| Type | Antibody |
| Immunogen |
CatNo: Ag3873 Product name: Recombinant human FXR1 protein Source: e coli.-derived, PGEX-4T Tag: GST Domain: 1-353 aa of BC028983 Sequence: MAELTVEVRGSNGAFYKGFIKDVHEDSLTVVFENNWQPERQVPFNEVRLPPPPDIKKEISEGDEVEVYSRANDQEPCGWWLAKVRMMKGEFYVIEYAACDATYNEIVTFERLRPVNQNKTVKKNTFFKCTVDVPEDLREACANENAHKDFKKAVGACRIFYHPETTQLMILSASEATVKRVNILSDMHLRSIRTKLMLMSRNEEATKHLECTKQLAAAFHEEFVVREDLMGLAIGTHGSNIQQARKVPGVTAIELDEDTGTFRIYGESADAVKKARGFLEFVEDFIQVPRNLVGKVIGKNGKVIQEIVDKSGVVRVRIEGDNENKLPREDGMVPFVFVGTKESIGNVQVLLEY Predict reactive species |
| Full Name | fragile X mental retardation, autosomal homolog 1 |
| Calculated Molecular Weight | 621 aa, 70 kDa |
| Observed Molecular Weight | 70-80 kDa |
| GenBank Accession Number | BC028983 |
| Gene Symbol | FXR1 |
| Gene ID (NCBI) | 8087 |
| RRID | AB_2110702 |
| Conjugate | Unconjugated |
| Form | Liquid |
| Purification Method | Antigen affinity purification |
| UNIPROT ID | P51114 |
| Storage Buffer | PBS with 0.02% sodium azide and 50% glycerol, pH 7.3. |
| Storage Conditions | Store at -20°C. Stable for one year after shipment. Aliquoting is unnecessary for -20oC storage. 20ul sizes contain 0.1% BSA. |
Background Information
Tumour necrosis factor-alpha (TNF-alpha) is a key mediator of inflammation in host defence against infection and in autoimmune disease. Its production is controlled post-transcriptionally by multiple RNA-binding proteins that interact with the TNF-alpha AU-rich element and regulate its expression; Fragile X mental retardation-related protein 1 (FXR1) is one of these. FXR1 (fragile-X-mental retardation-related protein 1) are RNA-binding proteins that have been demonstrated to impact miRNA-mediated, post-transcriptional gene regulation, and required for embryonic and postnatal development of muscle tissue. It can regulate intracellular transport and local translation of certain mRNAs. The FXR1 exists some isoforms with the MW 69 kDa and 60 kDa.
Protocols
| Product Specific Protocols | |
|---|---|
| IF protocol for FXR1 antibody 13194-1-AP | Download protocol |
| IHC protocol for FXR1 antibody 13194-1-AP | Download protocol |
| IP protocol for FXR1 antibody 13194-1-AP | Download protocol |
| WB protocol for FXR1 antibody 13194-1-AP | Download protocol |
| Standard Protocols | |
|---|---|
| Click here to view our Standard Protocols |
Publications
| Species | Application | Title |
|---|---|---|
Cancer Cell Integrative plasma and fecal metabolomics identify functional metabolites in adenoma-colorectal cancer progression and as early diagnostic biomarkers
| ||
Cell Competing Protein-RNA Interaction Networks Control Multiphase Intracellular Organization. | ||
Adv Sci (Weinh) Primate-Specific DAZ Regulates Translation of Cell Proliferation-Related mRNAs and is Essential for Maintenance of Spermatogonia | ||
Adv Sci (Weinh) The Spatial-Temporal Alternative Splicing Profile Reveals the Functional Diversity of FXR1 Isoforms in Myogenesis | ||
Neuron Fmr1 KO and fenobam treatment differentially impact distinct synapse populations of mouse neocortex. | ||
Nat Commun Microtubule-based transport is essential to distribute RNA and nascent protein in skeletal muscle |
Reviews
The reviews below have been submitted by verified Proteintech customers who received an incentive for providing their feedback.
FH Chao (Verified Customer) (01-30-2020) | Western blot show strong band in the basal state.
|